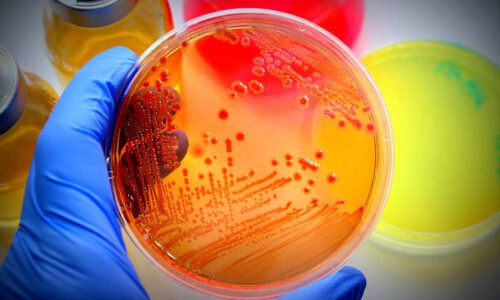
course thumbnail

Basic courses
Pharmacology
FeaturedThe Medical Pharmacology course provides medical students with an in-depth understanding of how drugs interact with living systems to prevent,
Only 90.00 $ including taxesPathoanatomy
FeaturedThe Medical Pathoanatomy course provides a comprehensive understanding of the structural changes in tissues and organs caused by disease, bridging
Only 50.00 $ including taxesPathophysiology
FeaturedThe Medical Pathophysiology course provides an integrated understanding of the mechanisms underlying human diseases and their clinical manifestations. It builds
Only 55.00 $ including taxesPhysiology
FeaturedThe Human Physiology course provides an in-depth study of the normal functions of the human body’s organ systems and the
Only 90.00 $ including taxesMicrobiology
FeaturedThe Medical Microbiology course provides an in-depth understanding of microorganisms and their vital role in human health and disease. It
Only 65.00 $20.00 $ including taxesBiochemistry
FeaturedThe Medical Biochemistry course explores the molecular and chemical foundations of life and their direct relevance to human health and
Only 80.00 $25.00 $ including taxesEmbryology
FeaturedThe Human Embryology course provides a comprehensive study of human development from fertilization to birth. The course emphasizes the sequential
Only 50.00 $15.00 $ including taxesHistology & Cytology
FeaturedCourse Description: The Histology and Cytology course provides a comprehensive study of the microscopic structure and organization of human cells
Only 50.00 $15.00 $ including taxesTopographical Anatomy
FeaturedThis course provides a comprehensive study of the regional (topographical) anatomy of the human body, emphasizing the spatial relationships between
Only 75.00 $20.00 $ including taxesHuman Anatomy
FeaturedCourse Overview: The Human Anatomy course provides medical students with a foundational understanding of the structure of the human body,
Only 55.00 $20.00 $ including taxes